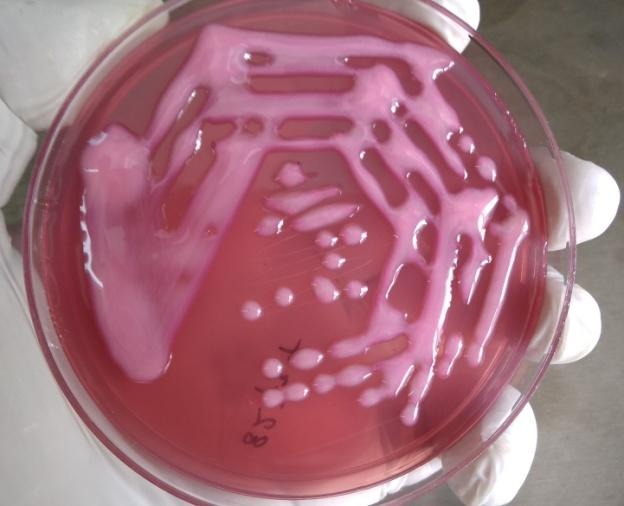
image 34

Klebsiella pneumoniae is a Gram-negative bacillus which is found mainly in the stool and respiratory tract of humans and is responsible for causing various illnesses from wound infections to pneumonia. They can turn into “superbugs” that are really hard to fight with antibiotics.

It was originally known as Friedlander’s bacillus after the name of German pathologist and microbiologist Carl Friendlander who isolated it from the lungs of people who died due to pneumonia in 1882. It was named Klebsiella in 1886 in honor of the work of German-Swiss microbiologist Edwin Klebs.
Taxonomy and Classification
Domain: Bacteria
Kingdom: Pseoudomonadati
Phylum: Pseudomonadota
Class: Gammaproteobacteria
Order: Enterobacterales
Family: Enterobacteriaceae
Genus: Klebsiella
Species: K. pneumoniae
Morphology and Microscopy
- Gram negative, cylindrical or rod-shaped
- Approximately 0.3-1µm*0.6-6µm arranged singly, in pairs or short chains
- Capsulated
- Non-sporing
- Non-motile
- Have parallel or bulging sides and rounded or slightly pointed ends
- Ciliated
Under microscope, it appears as pink colored cylindrical to rod shaped bacilli singly, in pairs or short chains.
Cultural and Growth Characteristics
- Optimum temperature:35˚C to 37˚C
- Optimum pH: 7.2
- Facultative anaerobes
- On Nutrient Agar: circular, 2-3mm, dome-shaped, mucoid, grayish white in color, translucent to opaque
- On Blood Agar: circular, 2-3mm, dome-shaped, mucoid, grayish white in color, translucent to opaque, non-hemolytic colonies.
- On Mac Conkey Agar: circular, 2-3mm, convex, mucoid, pink to red in color, opaque.
- On EMB Agar: circular, 2-3mm, convex, mucoid, pink to purple in color, translucent to opaque.
- On CLED Agar: large, mucoid colonies
Fig 1: Growth of Klebsiella pneumoniae on MacConkey Agar
Source:https://commons.wikimedia.org/wiki/File:Klebsiella_pneumoniae_Mucoid_Colonies_on_MacConkey_Medium.jpg
Biochemical and Identification Tests
| Tests | Results |
| Gram Staining | Positive |
| Catalase | Positive |
| Oxidase | Negative |
| O/F | Fermentative |
| Indole | Negative |
| MR (Methyl Red) | Negative |
| VP (Voges Proskauer) | Positive |
| Citrate | Positive |
| H2S | Negative |
| Motility | Negative |
| Gas | Positive |
| Gelatin Hydrolysis | Negative |
| Urease | Positive |
| TSIA | Acid/Acid |
| Nitrate Reduction | Positive |
| Growth in KCN | Positive |
| Fermentation of | |
| Glucose | Positive |
| Maltose | Positive |
| Glycerol | Positive |
| Lactose | Positive |
| Mannitol | Positive |
| Dnase | Negative |
| Arabinose | Positive |
| Cellobiose | Positive |
| Sucrose | Positive |
| Xylose | Positive |
| Inositol | Positive |
| Enzymatic Reactions | |
| Arginine Dehydrolase | Negative |
| Esculin Hydrolysis | Positive |
| Tyrosine Hydrolysis | Negative |
| Lipase | Negative |
| Lysine | Positive |
| Ornithine Decarboxylase | Negative |
| ONPG (β-galactosidase) | Positive |
| Acetoin Production | Variable |
| Phenylalanine Deaminase | Negative |
| Tryptophan Deaminase | Negative |
Pathogenesis and Virulence Factors
- Klebsiella infection is mainly transmitted through contact with bacteria from the respiratory tract or blood.
- The population which is vulnerable to infection by Klebsiella is patients with catheters, on ventilators or surgery.
- At the time of infection, K. pneumonia conquers both barriers (mechanical and chemical) as well as host defenses (cellular and humoral).
- After ingestion, the organism attacks the vulnerable cell, which is connected to pattern recognition.
- Soon after recognition, the receptor triggers the outcome of central vulnerable intercessors, and the ingrained vulnerable response participates in the monocyte or macrophage system.
- Additionally, the system has capacity for phagocytosis and manages the unsafe response to cytokines and product chemokines.
- Neutrophils are immune cells which are the first response towards infection.
- Essential cytokine proteins which have a crucial part in conversion of granulopoietic response are Interleukin-8 and Iinterleukin-23.
- Interleukin-12 stimulates the expression of Interleukin-17 by the production of interferon gamma.
- There are various virulence factors involved in pathogenesis which are explained below:
- Lipopolysaccharide:
- Possess lipid A core and O-polysaccharide antigen to withstand complement-mediated killing.
- Capsular Polysaccharide:
- Is the outer layer of the pathogen which possesses polymorphonuclear cells, which is responsible for resistance against phagocytosis.
- Reduces interaction between bacterial cells by decreasing the amount of C3 being put on the bacteria and acts as a barrier to block the connection among macrophage receptors and their ligands on the surface of bacteria.
- It regulates the interconnection between surfactant protein D (SP-D) and K. pneumoniae.
- SP-D moderate aggregation and enhance phagocytic removal by human alveolar macrophages.
- C3 and SP-D cannot bind which cause clearance of microorganism from lower respiratory tract, causing pneumonia.
- Capsular Antigen:
- It is composed of complex acidic polysaccharides, which is important in virulence of pathogens.
- As a process of protection, the bacterium eludes phagocytosis by using thick bundles of fibrillous structure by polymorphonuclear granulocytes.
- This process also blocks killing by bactericidal serum factors and obstructs complement constituents like C3b which is responsible for opsonization of the pathogen.
- These virulence factors have the capacity to hamper the differentiation capacity of macrophages in vitro.
- Fimbriae:
- Type 1 fimbriae is responsible for the formation of intracellular bacterial communities.
- Type 3 fimbriae play a crucial role in formation of biofilm on biotic and abiotic surfaces.
- Biofilm Formation:
- Promotes resistance to host killing and antibiotics.
- Siderophores:
- Acquire iron from the host cell to permit propagation of the infecting organism.
- Enterotoxins
- These are the proteins that are similar to enteroaggregative E. coli heat stable enterotoxin 1, heat stable and heat liable enterotoxins.
- Multidrug-resistant strains which contain plasmids carrying enterotoxin-coding genes are responsible for emergence of epidemics.
- Urease:
- Have a limited role in precipitation of inorganic salts causing catheter encrustation.

Fig 2: Virulence Factors of Klebsiella pneumoniae
Source: https://link.springer.com/article/10.1007/s12088-024-01247-0
Epidemiology and Transmission
The primary reservoir of K. pneumoniae is human, among which 1-6% carry organism in the nasopharynx while 5-38% have organism in their stomach. The higher rate of colonization is reported in Chinese ethnicity and in those who have chronic alcoholism. K. pneumoniae carrier rate is much higher in hospitalized patients than in the community. One study showed a carrier rate as high as 77% in the stool of hospitalized patients and are related to the amount of antibiotics used. The K. pneumoniae associated pneumonia is classified as hospital-acquired and community-acquired pneumonia. It is estimated that 3-5% of all community-acquired pneumonia is associated with K. pneumoniae in Western Culture, while the rate is 15% in developing countries like Africa. Worldwide 11.8% of all hospital-acquired pneumonia is associated with K. pneumoniae. About 8-12% of people develop pneumonia because of K. pneumoniae while on a ventilator whereas only 7% occurs in people who are not ventilated. People with septicemia and alcoholism show mortality rates between 50-100%.
People using antibiotics for long duration of time, patients with medical devices like catheters, ventilators, people having health problems like cancer, diabetes, kidney failure, lung disease, old, aged people, person with weakened immune system, person with recent surgery of abdomen, are at risk with K. pneumoniae infection. Klebsiella pneumoniae is not an air-borne pathogen and spreads mainly through following ways:
- Through contaminated water and soil.
- Spread through person to person contact especially through fecal-oral routes.
- Through the hands of people working in healthcare settings.
- Via contact with objects such as contaminated medical equipment (such as catheter or ventilator) and surfaces.
- Through respiratory droplets from sneezing or coughing.
- Spread by the consumption of contaminated food.
- Through wounds caused by injury and surgery.
Types of K. pneumoniae
There are basically two types of K. pneumoniae:
- Classic
- They usually live in the body and don’t harm.
- They spread in hospitals and long-term care facilities.
- Usually infect immunocompromised people or people with medical devices.
- Hypervirulent
- They spread outside healthcare facilities and are responsible for causing severe illness.
Clinical Manifestations
K. pneumoniae can cause infections to various parts of body and depending on body parts symptoms may vary which are explained below:
- Symptoms of meningitis
- Severe headache
- Confusion
- Stiffness in neck
- Sudden rise in fever
- Vomiting and discomfort in stomach
- Light Sensitivity
- Difficulty in waking up and drowsiness
- Seizures
- Loss of appetite, thirst or both
- Symptoms of UTIs
- Urgency to urinate
- Frequency to urinate
- Pain during urination
- Blood in urine
- Pain under pubic bone
- Symptoms of liver abscesses
- Chills
- Fever
- Pain in upper right side of stomach
- Symptoms of Bloodstream Infections
- Chills
- Fever
- Low blood pressure
- Fast heart rate
- Abdominal pain
- Confusion
- Nausea and Vomiting
- Fast Breathing
- Rashes in skin
- Hypothermia or low body temperature
- Diarrhea
- Dizziness
- Delirium
- Symptoms of wound and surgical infections
- Warmth and Fever
- Slowness in healing
- Swelling and Redness
- Pain
- Pus flowing from wound
- Symptoms of Skin infection
- Redness and Swelling
- Pain
Laboratory Diagnosis
- Sample Collection
Depending on the site of infection, the sample is determined.
| Infection | Specimen |
| UTI | Mid Stream Urine |
| Respiratory Infection | Sputum |
| Bacteremia | Blood |
| Wound | Pus |
| Meningitis | Cerebro Spinal Fluid |
- Gram Staining
- Appears as pink cylindrical or rod shaped either singly, in pairs or in short chains.
- Culture
- Specimens are inoculated on suitable culture media.
- Then the inoculated plates are incubated at 37˚C for 24hrs.
- On Blood Agar: mucoid, slimy, non-hemolytic colonies.
- On MacConkey Agar: mucoid, lactose fermenting pink colored colonies
- On EMB Agar: mucoid, large, pink to purple colored colonies with no metallic green sheen.
- On CLED Agar: mucoid, large colonies.
- Biochemical Tests
After culture, colonies from incubated plates are performed for biochemical tests and identified as K. pneumoniae based on following results:
| Tests | Result |
| Catalase | Positive |
| Oxidase | Negative |
| Indole | Positive |
| MR (Methyl Red) | Positive |
| VP (Voges Proskauer) | Negative |
| Citrate | Negative |
| H2S | Negative |
| Motility | Motile |
| Gas | Positive |
| O/F | Fermentative |
- String Test:
- If the colony stretches more than 5mm when touched and lifted vertically with an inoculating loop it tests positive for hypermucoviscosity of K. pneumoniae.
- India Ink Capsule Staining
- The bacterial cell stains purple while the background will remain dark.
- The capsule present will appear clear against the dark background.
Treatments
- For Urinary Tract Infections
- Antibiotics such as trimethoprim-sulfamethoxazole, cephalosporins and tetracyclines are used as primary antibiotics for treatment.
- As an alternative antibiotic, aminoglycosides, amoxicillin or ampicillin are used.
- For other infections
- Fluoroquinolones or Cephalosporins are used as primary antibiotics.
- Aminoglycosides, imipenem, aztreonam or colistin are used as an alternative.
Prevention and Control
K. pneumoniae infections can be controlled and prevented by following ways:
- Always wash hands before eating, touching eyes, nose or mouth and before changing bandages on wounds.
- Ensure proper washing of hands after using the bathroom, coughing, sneezing or touching anything in a hospital setting.
- Proper disinfection of surfaces before touching.
- Proper sterilization of medical devices before using.
- Ensure proper consumption of antibiotics.
- Avoid contact with sick people.
- Avoid sharing objects with an infected patient.
- Wash hands before and after contact with patients in the hospital.
- Use gloves and protective mask when coming in contact with an infected patient.
Antibiotic Resistance
K. pneumoniae is considered a superbacteria which is resistant to most antimicrobial agents. One of the most important aspects of K. pneumoniae is its tendency to obtain antibiotic resistance. K. pneumoniae develop resistance mainly by: increased efflux, drug inactivation, alteration in antibiotic target site, biofilm formation, porin loss and mutation. Majority of K. pneumoniae produce extended spectrum β-lactamase that disable broad-spectrum antibiotics such as Cephalosporins and β-lactams. Hence, Carbapenem antibiotic groups are regarded as the last option for treatment. However, this bacterium has also developed resistance against antibiotics known as Carbapenems by producing an enzyme called Carbapenemase. This resistant strain has become a global health issue because of its capacity to expand rapidly within the hospital setting leading to outbreaks and increased mortality among infected patients. Infections caused by Carbapenem-Resistant Klebsiella pneumoniae (CRKP) are related to limited treatment alternatives, directing the search of new antimicrobial agents and approach to fight against these issues.
Conclusion
K. pneumoniae is a most significant member of the genus klebsiella (enterobacteriaceae) which is an opportunistic pathogen that can infect humans by colonizing mucosal surfaces which then spread to other parts of the body. They are most commonly found in gastrointestinal tract and hands of hospital personnel and are responsible for nosocomial infection causing pneumonia, liver abscesses, soft tissue infections, urinary tract infections, bacteremia to death in some cases. Overuse or misuse of antibiotics, people with health problems like cancer, diabetes, kidney failure, lung disease, old age people, are at risk of infection by K. pneumoniae.
References
- Ochońska, D., & Brzychczy-Włoch, M. (2024). Klebsiella pneumoniae – taxonomy, occurrence, identification, virulence factors and pathogenicity. Advancements of Microbiology, 63(3), 157–175. https://doi.org/10.2478/am-2024-0014
- Microbiology in Pictures. (n.d.). Klebsiella pneumoniae. https://www.microbiologyinpictures.com/klebsiella%20pneumoniae.html
- Riwu, K. H. P., Effendi, M. H., Rantam, F. A., Khairullah, A. R., & Widodo, A. (2022). A review: Virulence factors of Klebsiella pneumonia as emerging infection on the food chain. Veterinary World, 15(9), 2172–2179. https://doi.org/10.14202/vetworld.2022.2172-2179
- Li, B., Zhao, Y., Liu, C., Chen, Z., & Zhou, D. (2014). Molecular pathogenesis of Klebsiella pneumoniae. Future Microbiology, 9(9), 1071–1081. https://doi.org/10.2217/fmb.14.48
- Ashurst, J. V., & Dawson, A. (2023). Klebsiella pneumonia. In StatPearls [Internet]. StatPearls Publishing. Retrieved January 30, 2026, from https://www.ncbi.nlm.nih.gov/books/NBK519004/
- Biolabtests. (n.d.). Microbial top facts: Klebsiella pneumoniae. https://biolabtests.com/microbial-top-facts-klebsiella-pneumoniae/
- Cleveland Clinic. (2025, September 15). Klebsiella pneumoniae infection: Causes & symptoms. https://my.clevelandclinic.org/health/diseases/klebsiella-pneumoniae
- WebMD. (2023, November 21). Klebsiella pneumoniae infections: Symptoms and treatments. https://www.webmd.com/a-to-z-guides/klebsiella-pneumoniae-infection
- Tua Saúde. (2024, October 11). Klebsiella pneumoniae: Symptoms, transmission & treatment. https://www.tuasaude.com/en/klebsiella-pneumoniae/
- Sharma, M. (2023). Diagnosis and treatment of Klebsiella pneumoniae infections. Applied Microbiology: Open Access, 9, 271. https://www.longdom.org/open-access/diagnosis-and-treatment-of-iklebsiella-pneumoniaei-infections-103376.html
